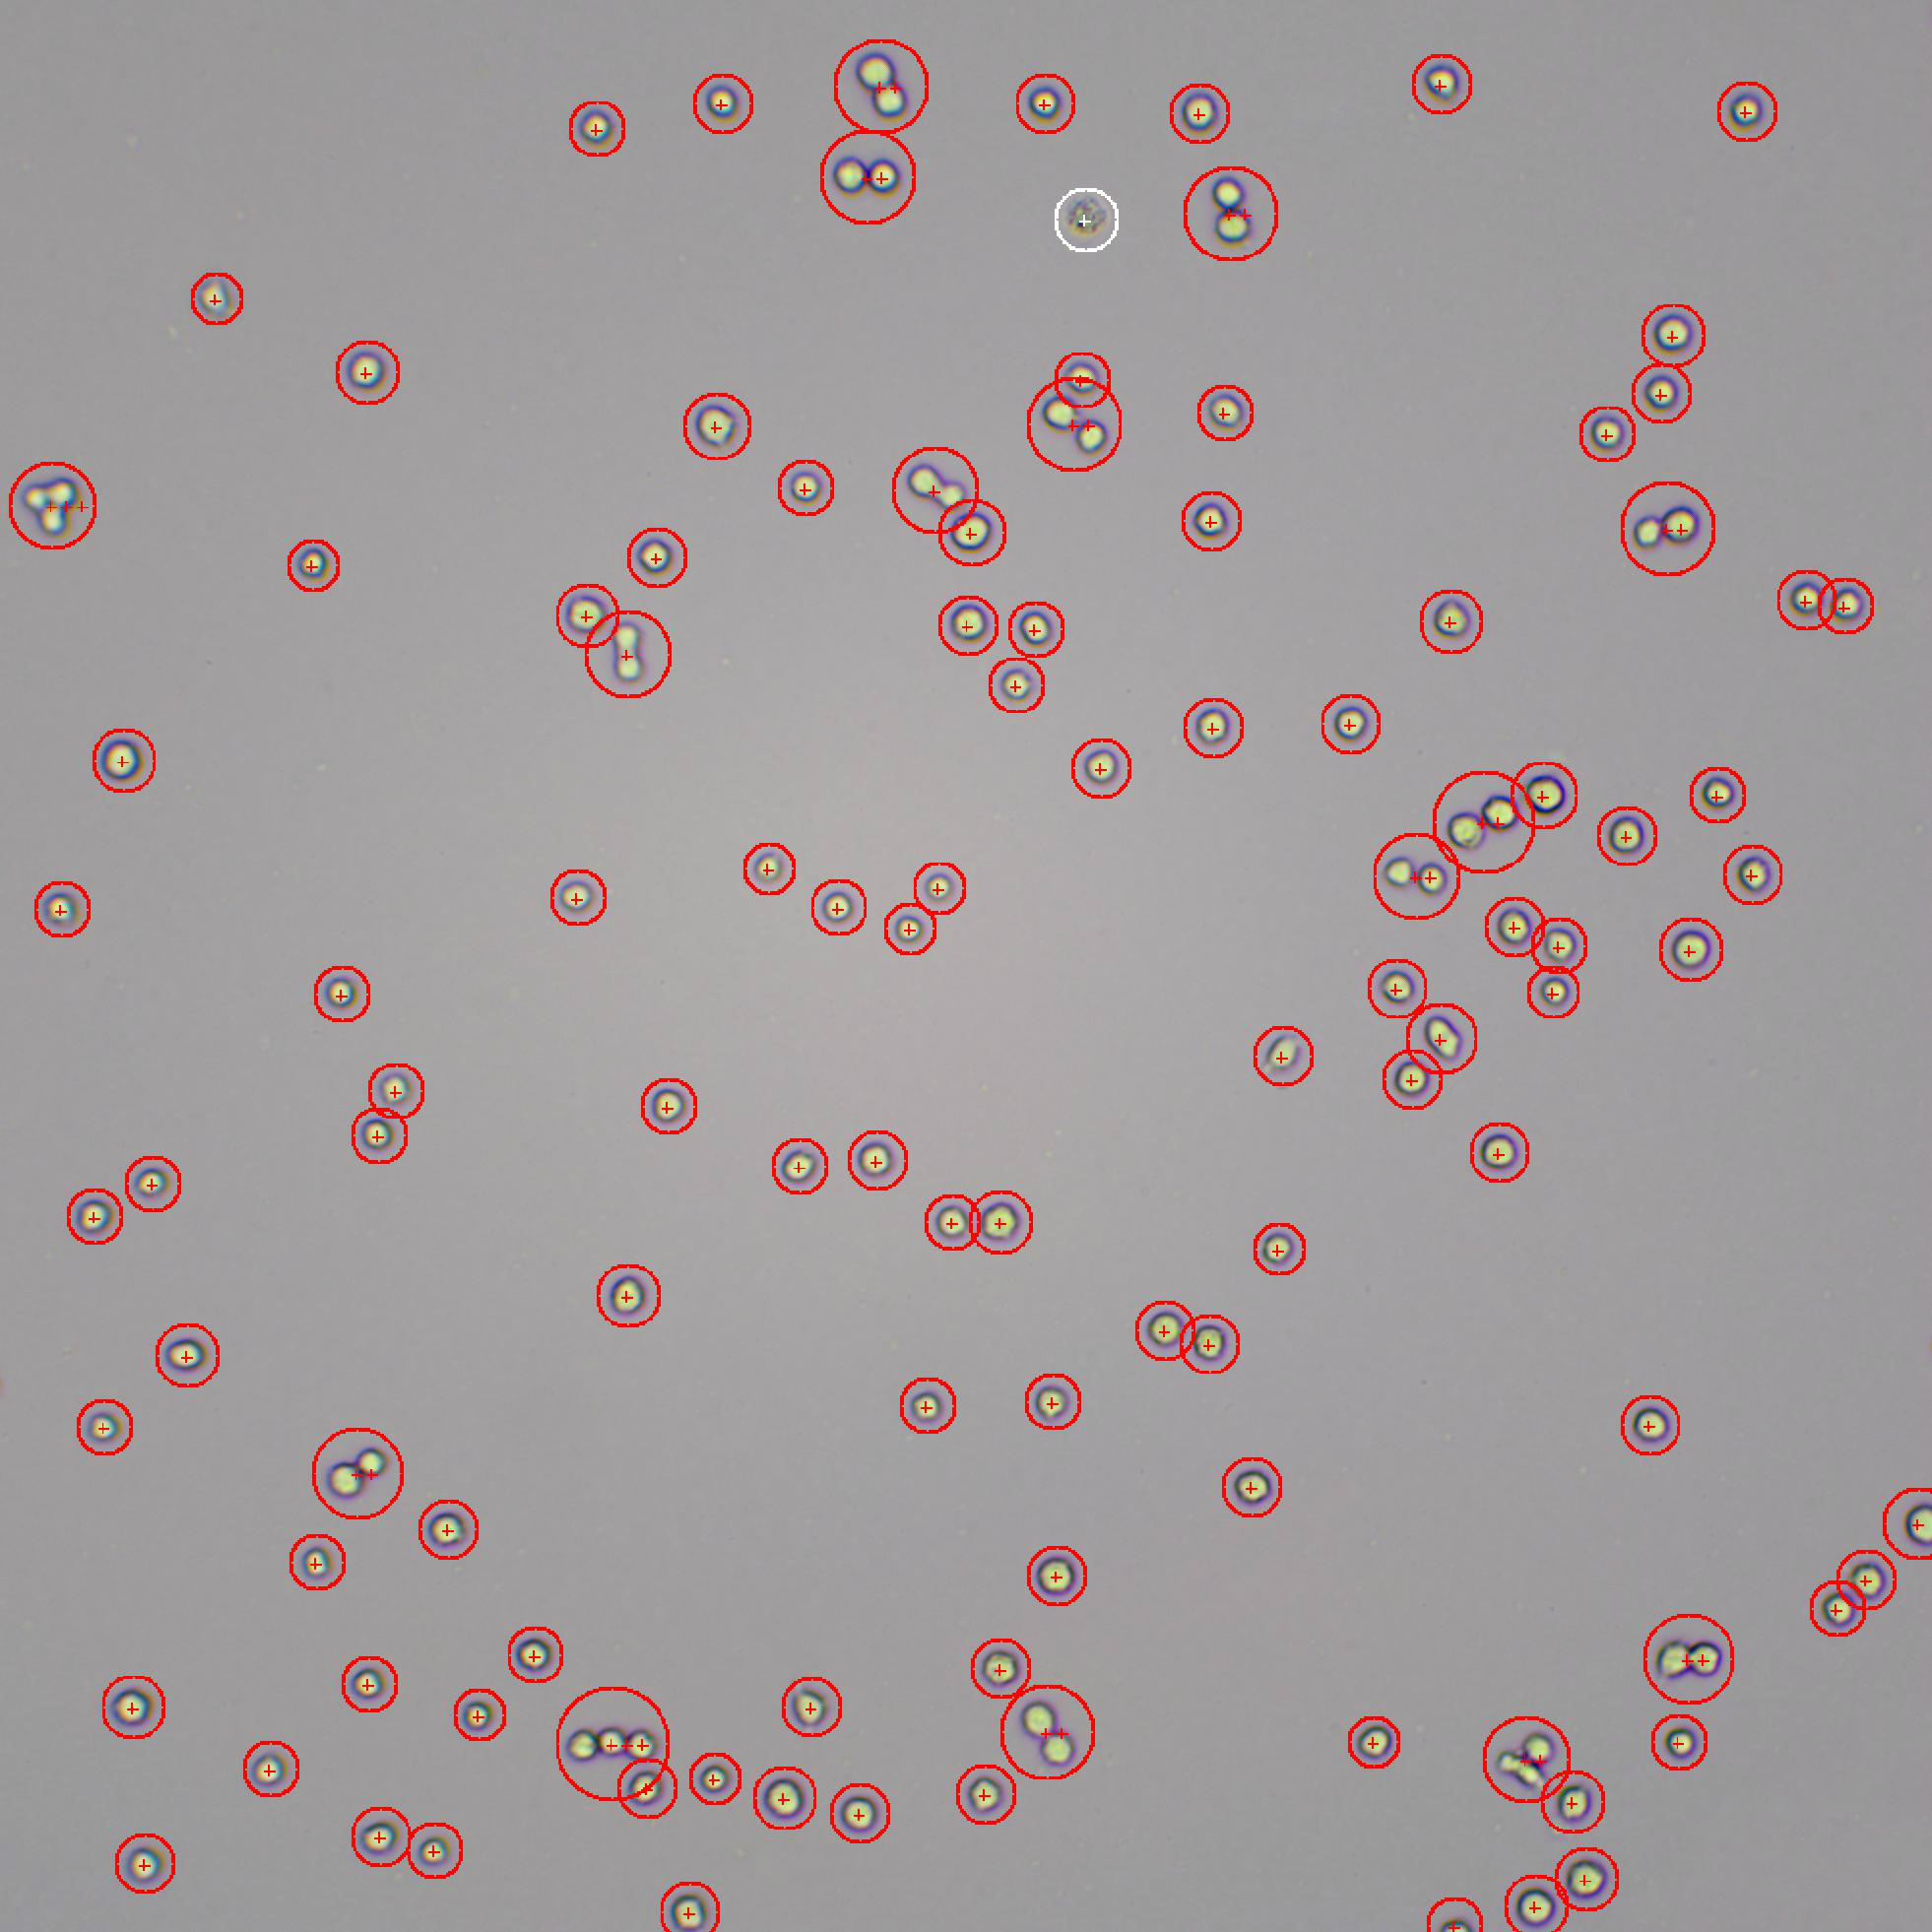
0),无需台盼蓝染色亦可区分死活细胞;特别适用于活体细胞观察,避免

蓝细胞图片及名称

蓝藻细胞模式图
图片尺寸300x233
1.2细胞多样性和统一性知识点
图片尺寸1087x423
蓝细胞 | 涂抹细胞 | 血细胞形态学检查 9702 0669♂15
图片尺寸960x1280
田田快乐的博客
图片尺寸394x309
0),无需台盼蓝染色亦可区分死活细胞;特别适用于活体细胞观察,避免
图片尺寸1962x1962
看图识细胞第91期
图片尺寸750x563
蓝色细胞背景
图片尺寸1024x1024
这是之前用台盼蓝染色后的图片,请问图中的蓝色的细胞是被染色的死
图片尺寸3264x2448
细胞活力鉴定——台盼蓝染色法 - 蓝色创想 - 蓝色创想
图片尺寸750x559
染色状态下,可见肥大细胞的细胞质内有大量蓝紫色的嗜碱性小颗粒,组胺
图片尺寸631x476
细胞胞质中残留有核糖体等嗜碱性物质,在瑞氏/瑞吉染色下,呈现蓝紫/蓝
图片尺寸750x750
深蓝色背景上的细胞分裂插画图片素材
图片尺寸612x408
团块细胞计数的图像台盼蓝染色方法台盼蓝是一种偶氮染料,只能染色死
图片尺寸660x305
显微镜下的蓝色有机细胞
图片尺寸1100x1100
基因,细胞核,染色体,高光,几何,计算机图形,合成,图画,画,红色,蓝色
图片尺寸819x614
球体,细菌,抽象,蓝色,球菌,细胞,概念
图片尺寸350x350
预防疾病背景图片_蓝色研究医学基因细胞背景
图片尺寸720x300
生命dna显微镜下的蓝色细胞. 生命和生物学,医学科学,分子研究dna.
图片尺寸450x300
按病毒细胞排列死亡细胞排列绿色按病毒蓝细胞排列死亡
图片尺寸533x300
蓝细胞显微视图
图片尺寸1100x1100